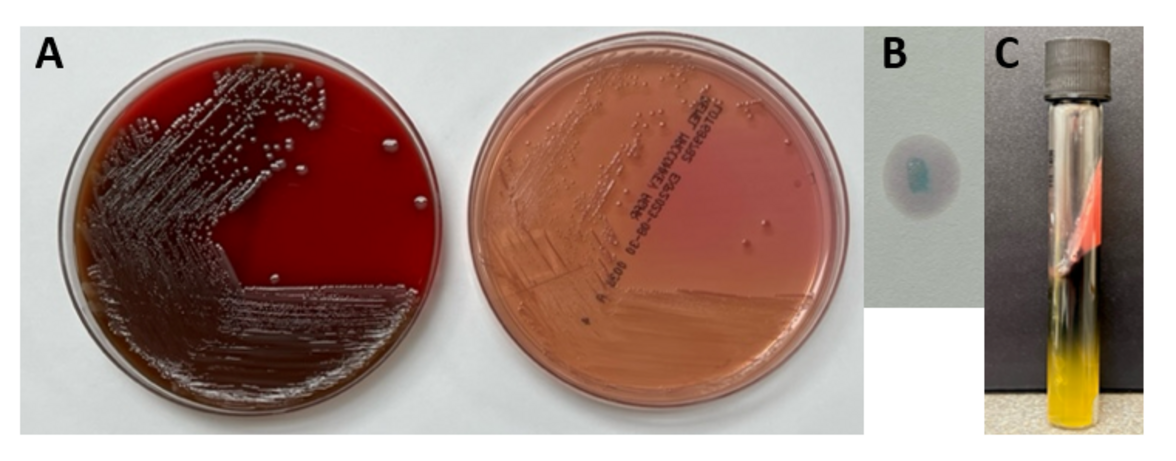

Мужчина 53 лет поступил в отделение неотложной помощи с однодневным недомоганием, двусторонней болью в подреберье и снижением мочеиспускания.
В анамнезе - декомпенсированный цирроз печени вследствие употребления алкоголя, осложненный варикозным расширением вен пищевода и язвами желудка, перитонеальный асцит, несколько недавних эпизодов кровотечения из верхних отделов ЖКТ, моноклональная гаммопатия неизвестного происхождения и перенесенная простатэктомия вследствие рака простаты. Устный анамнез показал, что незадолго до поступления пациент активно пил и недавно употреблял устрицы, запеченные креветки и крабовое мясо. Во время осмотра в отделении неотложной помощи у пациента быстро развился септический шок.
Лабораторные исследования при поступлении показали тяжелый метаболический ацидоз, панцитопению и острую почечную недостаточность. Первичная КТ брюшной полости/таза показала цирротические изменения печени, варикозное расширение вен и утолщение стенок дистального отдела пищевода, двусторонние перинефральные жировые тяжи, распространяющиеся на таз, и перивезикальный жир. Пациент был госпитализирован в отделение интенсивной терапии для интубации/искусственной вентиляции легких и введения нескольких прессоров, а также эмпирического меропенема, ванкомицина и микафунгина, учитывая опасения септического шока. Первоначальный посев крови, взятый в отделении реанимации, был положительным с грамотрицательными палочками (как аэробными, так и анаэробными) менее чем через 24 часа после посеваа.
Лабораторная идентификация
Культуры крови были взяты на анализ и молекулярную идентификацию. С помощью коммерческой мультиплексной молекулярной ПЦР панели образца положительной культуры крови не удалось провести идентификацию. Последующий рост микроорганизма на агаре Макконки через 18 часов выявил колонии не ферментирующие лактозу (изображение 1A). Микроорганизм был отрицательным по оксидазе, положительным по каталазе и индолу (изображение 1B) и демонстрировал выработку сероводорода при инокуляции на среду с тройным сахарным железом. Микроорганизм был окончательно идентифицирован как Edwardsiella tarda с помощью MALDI-TOF MS и был широко чувствителен ко всем протестированным антибиотикам, включая бета-лактамы и фторхинолоны.
Обсуждение
Edwardsiella tarda - редко выделяемый представитель рода Enterobacterales, который в большинстве случаев ассоциируется с гастроэнтеритом. Все чаще появляются сообщения о дополнительных проявлениях, включая перитонит, внутрибрюшной абсцесс и раневые инфекции. Бактериемия встречается редко и может привести к холангиту, холециститу и абсцессу печени путем гематогенного распространения. Пациенты пожилого возраста (>65 лет) и пациенты с заболеваниями гепатобилиарной системы, включая цирроз печени, злоупотребление алкоголем и нарушения метаболизма железа, подвержены повышенному риску внекишечных форм инфекции. Колонизация желудочно-кишечного тракта, как полагают, может даже стать предрасполагающим фактором, ведущим к бактериемии. Случаи гастроэнтерита обычно проходят сами собой, хотя при затяжном течении можно использовать ципрофлоксацин или триметоприм/сульфаметоксазол. Быстрая и точная диагностика бактериемии E. tarda очень важна, так как эта инфекция связана с повышенной летальностью, особенно среди пациентов с заболеваниями печени.
Как представители рода Enterobacterales, Edwardsiella sp. имеют общие биохимические особенности с другими представителями этого рода, в том числе обладают каталазоположительной и оксидазоотрицательной активностью. Отрицательная оксидаза помогает отличить E. tarda от Aeromonas/Plesiomonas - обоих видов, которые также ассоциируются с водной средой и вызывают желудочно-кишечные инфекции. E. tarda не ферментирует лактозу и восстанавливает серосодержащие аминокислоты до сероводорода. Это может привести к путанице с представителями рода сальмонелл, поскольку колонии имеют схожий внешний вид на средах, включая гектоген агар и ксилозо-лизиновый дезоксихолатный агар, предназначенный для восстановления и предположительной идентификации Salmonella из образцов желудочно-кишечного тракта. Важно отметить, что E. tarda также является индол-положительной, что позволяет биохимически дифференцировать эти два рода.
E. tarda ассоциируется с пресноводной или солоноватой водной средой. Этот микроорганизм является хорошо известным патогеном аквакультуры, вызывая серьезные инфекции у рыб и нанося значительный экономический ущерб. Для предотвращения заражения водных животных E. tarda используются вакцины и профилактические антибиотики. Инфицирование человека часто связано с употреблением зараженной рыбы и морепродуктов, а диагностика почти полностью зависит от микробиологической культуры. Клинические мультиплексные молекулярные панели для выявления инфекций желудочно-кишечного тракта и кровотока не способны обнаружить E. tarda. В случае данного пациента наиболее вероятным событием, приведшим к колонизации желудочно-кишечного тракта E. tarda, является недавнее употребление морепродуктов, что согласуется с ранее зарегистрированными случаями бактериемии E. tarda.
Пациента лечили меропенемом, который впоследствии был заменен пиперациллином/тазобактамом, а посевы крови очистились. Пациент был отключен от прессоров и экстубирован. К сожалению, в течение трех недель пациент декомпенсировался из-за усугубления шока и ацидоза и вскоре скончался.